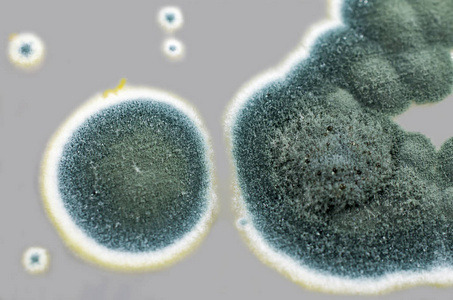
真菌菌落青霉菌菌落在沙氏葡萄糖琼脂上的研究照片
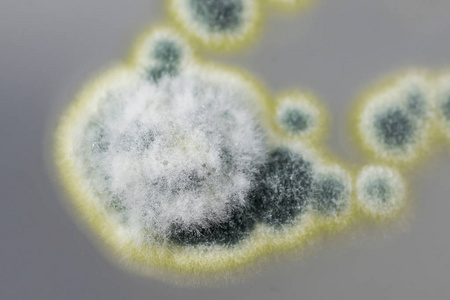
青霉菌菌落在沙氏葡萄糖琼脂上的研究照片

青霉菌落

sabouraud dextrose琼脂上青霉菌菌落
图片尺寸1200x795
第四天菌落,青霉,是真的感染吗?查了东科老师的书,请教群内大咖
图片尺寸1600x1200
真菌菌落青霉菌菌落在沙氏葡萄糖琼脂上的研究照片
图片尺寸323x300
sabouraud dextrose琼脂上青霉菌菌落
图片尺寸1200x795
菌落外形和测序blast结果不一致,怎么办 yankun241 07-21 11:57
图片尺寸2448x3264
香肠表面的青霉菌菌落
图片尺寸1200x795
青霉菌
图片尺寸1280x960
sabouraud dextrose琼脂上青霉菌菌落
图片尺寸1200x795
sabouraud dextrose琼脂上青霉菌菌落
图片尺寸1200x800
香肠表面的青霉菌菌落
图片尺寸1200x801
青霉菌,子囊真菌是重要的自然环境以及食品和药物生产.
图片尺寸1200x800
香肠表面的青霉菌菌落
图片尺寸1200x795
香肠表面的青霉菌菌落
图片尺寸1200x795
青霉菌,子囊真菌是重要的自然环境以及食品和药物生产.
图片尺寸1200x800
第一种发现并用于疾病治疗的天然抗生素药物是青霉素.
图片尺寸900x661
真菌(青霉)纯化问题 - 微生物 - 实验/技术 - 小木虫论坛-学术科研
图片尺寸592x444
真菌菌落青霉菌菌落在沙氏葡萄糖琼脂上的研究照片
图片尺寸453x300
实验室状态下的淡紫拟青霉菌落
图片尺寸600x397
青霉菌菌落在沙氏葡萄糖琼脂上的研究照片
图片尺寸450x300
绳状青霉在pda上的菌落特征
图片尺寸446x352